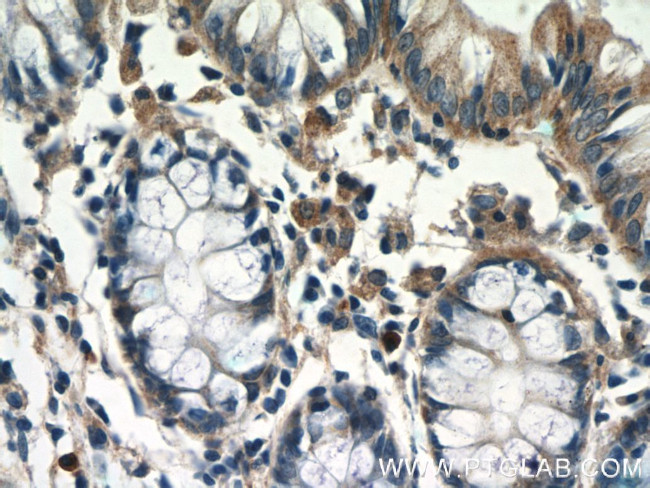
TSPAN1 Antibody in Immunohistochemistry (Paraffin) (IHC (P))

Search
Proteintech
TSPAN1 Polyclonal Antibody
{{$productOrderCtrl.translations['antibody.pdp.commerceCard.promotion.promotions']}}
{{$productOrderCtrl.translations['antibody.pdp.commerceCard.promotion.viewpromo']}}
{{$productOrderCtrl.translations['antibody.pdp.commerceCard.promotion.promocode']}}: {{promo.promoCode}} {{promo.promoTitle}} {{promo.promoDescription}}. {{$productOrderCtrl.translations['antibody.pdp.commerceCard.promotion.learnmore']}}
产品信息
16058-1-AP
种属反应
宿主/亚型
分类
类型
抗原
偶联物
形式
浓度
规格
纯化类型
保存液
内含物
保存条件
运输条件
产品详细信息
Immunogen sequence: MQCFSFIKT MMILFNLLIF LCGAALLAVG IWVSIDGASF LKIFGPLSSS AMQFVNVGYF LIAAGVVVFA LGFLGCYGAK TESKCALVTF FFILLLIFIA EVAAAVVALV YTTMAEHFLT LLVVPAIKKD YGSQEDFTQV WNTTMKGLKC CGFTNYTDFE DSPYFKENSA FPPFCCNDNV TNTANETCTK QKAHDQKVEG CFNQLLYDIR TNAVTV (1-215 aa encoded by B C013404)
靶标信息
The protein encoded by this gene is a member of the transmembrane 4 superfamily, also known as the tetraspanin family. Most of these members are cell-surface proteins that are characterized by the presence of four hydrophobic domains. The proteins mediate signal transduction events that play a role in the regulation of cell development, activation, growth and motility.
仅用于科研。不用于诊断过程。未经明确授权不得转售。
生物信息学
蛋白别名: tetraspan 1; Tetraspan NET-1; Tetraspanin TM4-C; Tetraspanin-1; tetraspanin; transmembrane 4 super family; transmembrane 4 superfamily member; Tspan-1; unnamed protein product
基因别名: 9030418M05Rik; NET1; TM4C; TM4SF; TSPAN1
UniProt ID: (Human) O60635, (Mouse) Q99J59, (Rat) Q6AYR9
Entrez Gene ID: (Human) 10103, (Mouse) 66805, (Rat) 298436